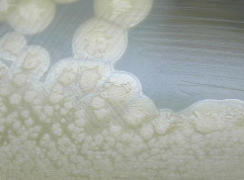
靶向梭菌神经毒素作为治疗慢性疾病的新型药物 中网时尚,stylechina.com

据科学家报道,地球上最剧毒的物质已经被小剂量用于治疗某些神经系统疾病和面部皱纹。
可以重新设计,以扩大其在帮助数百万类风湿性关节炎,哮喘,牛皮癣和其他疾病患者中的作用。 他们的研究发表在ACS的生物化学杂志上。
埃德温·查普曼(Edwin Chapman)及其同事解释说,肉毒梭菌会产生毒素或毒物细菌是罕见但严重的食物中毒形式,是科学上已知的最有力的毒素。
但是,医生可以注射小剂量来阻止神经递质或化学信使的释放,从而将信号从一种神经细胞传递到另一种神经细胞。毒素会破坏神经细胞中的一种蛋白质,该蛋白质介导神经递质的释放,破坏神经信号,从而导致某些疾病中的疼痛,肌肉痉挛和其他症状。
该蛋白质不仅存在于神经细胞中,而且还存在于人体的其他细胞中。但是,这些非神经细胞缺乏肉毒杆菌毒素进入和工作所需的受体。
查普曼(Chapman)的研究小组试图通过将肉毒杆菌毒素钩到可以附着在其他细胞上的受体的分子上来扩大其潜在用途。
他们的实验室实验表明,这些工程改造的肉毒杆菌毒素确实可在非神经细胞中起作用,从而阻止了与炎症相关的免疫细胞释放蛋白质,而炎症是多种疾病背后的潜在驱动力。
这种肉毒杆菌毒素疗法在一系列慢性炎性疾病和其他疾病中具有潜力,这可能会扩大这些材料在医学中的作用。